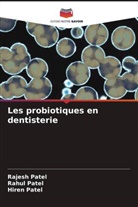
Hiren Patel, Rahul Patel, Rajesh Patel - Les probiotiques en dentisterie
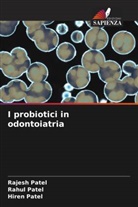
Hiren Patel, Rahul Patel, Rajesh Patel - I probiotici in odontoiatria

Search result
SECONDARY DEFORMITIES OF CLEFT LIP AND PALATE AND IT'S CORRECTION
English
20.05.2025
Paperback / Softback
Fr. 117.00
Bacillus thuringiensis: Status of Insect Pathogen From Middle Gujarat
English
01.01.2013
Paperback / Softback
Fr. 92.00
Deformità secondarie del labbro leporino e del palato e la sua correzione
Italian
31.07.2025
Paperback / Softback
Fr. 117.00
Sekundäre Deformitäten der Lippen-Kiefer-Gaumenspalte und deren Korrektur
German
01.01.2025
Paperback / Softback
Fr. 117.00
Wtórne deformacje rozszczepu wargi i podniebienia oraz ich korekcja
Polish
01.01.2025
Paperback / Softback
Fr. 117.00
Deformidades secundárias da fissura labiopalatina e sua correção
Portuguese
01.01.2025
Paperback / Softback
Fr. 117.00
Déformations secondaires de la fente labio-palatine et sa correction
French
01.01.2025
Paperback / Softback
Fr. 117.00
Deformidades secundarias del labio y paladar hendido y su corrección
Spanish
31.07.2025
Paperback / Softback
Fr. 117.00
Optimization of fermentation medium of cellulase with fungal isolates
English
01.01.2014
Paperback / Softback
Fr. 71.00
Ingredients for Successful System Level Design Methodology
English
18.10.2010
Paperback / Softback
Fr. 135.00
SystemC Kernel Extensions for Heterogeneous System Modeling
English
21.10.2010
Paperback / Softback
Fr. 135.00